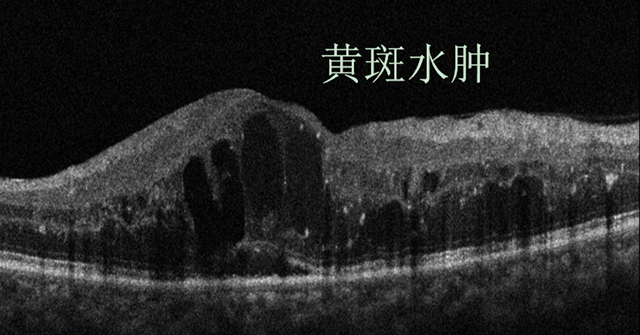
微信图片_20240321091229.png

川南在线 发布时间:2024-03-21
3月15日,在西南医科大学附属医院眼科,由主任吕红彬教授带领科室玻璃体腔注药团队,在“一站式玻璃体腔注药中心”完成了三位糖尿病黄斑水肿(DME)患者的眼底病创新药物的注射,这也是双特异性抗体法瑞西单抗在川南地区的首次注射,这标志着在区域内眼底疾病的治疗,将开启双通路治疗的全新时代。


吕红彬教授为患者注射法瑞西单抗
据了解,法瑞西单抗是全球首个眼内注射的双特异性抗体药物,于2023年底先后在我国获批用于治疗DME和新生血管性(湿性)年龄相关性黄斑变性(nAMD)。其可同时靶向抑制引起多种视网膜疾病的关键致病因子血管生成素-2(Ang-2)和血管内皮生长因子A(VEGF-A),在原有抗VEGF药物的基础上,同时结合并抑制Ang-2/VEGF-A两条通路,在增强血管稳定性的同时减少血管渗漏,实现内外双重消除渗漏、稳定血管的作用。
吕红彬教授介绍到:“十四五”全国眼健康规划已经正式将眼底病新增为重要防治病种,并明确提出要重点关注糖尿病视网膜病变和黄斑变性等人群,降低疾病负担和致盲率。DME和nAMD引起的致盲和低视力已成为重大公共卫生问题,目前单通路眼内抗VEGF药物存在部分应答不良、频繁注射等不足,致使部分眼底病患者未能取得理想的治疗结局。多项全球III期临床研究结果表明,约80%的DME和nAMD患者,在接受双通路疗法后,其治疗间隔可延长至3-4个月,维持较长时间不复发。
“双通路眼内注射药物的临床应用是DME和nAMD治疗的重要里程碑,期待该药物的应用能造福更多的川南乃至川渝滇黔结合部区域的眼底病患者,为他们带来更好的视觉质量和良好的生活品质。”吕红彬教授说到。

糖尿病黄斑水肿(DME)
什么是DME?
糖尿病患者长期处于高血糖状态,导致视网膜内屏障破坏和血管通透性增加,血液中的水分子以及一些蛋白成分就容易穿过已经受损的血管壁,在视网膜组织内或视网膜下出现异常聚集,如果液体积聚在黄斑区,则导致黄斑水肿。

DME患者的症状
DME进展隐匿且缓慢,在早期患者通常并无明显症状,但随着水肿程度的逐渐加重,患者除了自觉视力减退以外,还会出现看东西变弯曲、变小、变暗等,此时DME患者的视功能已经出现了明显的受损,必须及时进行治疗。
DME怎么治疗?
玻璃体腔内注射抗VEGF药物是DME的一线治疗方法,其能改善视网膜血管的通透性并减轻黄斑水肿,安全性高。目前多个指南推荐采用每月玻璃体腔注射抗VEGF药物1次,连续注射3~6次后进入按需治疗。
但由于糖尿病的持续存在,DME可能因血糖的波动和治疗不规范而反复出现。因此,抗VEGF药物治疗DME不是一针灵,而是需要定期随访并按需治疗。
此外,有一部分患者治疗后仍可能存在持续性黄斑水肿,即抗VEGF药物治疗应答不良或无应答,这也导致了DME患者依从性缺乏和视力丧失几率的增加,同时也增加了社会和经济负担。
DME患者应该控制好血糖、血压、血脂和体重,养成良好的生活方式,严格遵医嘱定期复查。一般来说,每次复查项目包括:视力、眼压、裂隙灯、眼底照相或者荧光眼底血管造影检查、黄斑OCT/OCTA等。
总的来说DME患者需要严格控制好血糖、血压和血脂,定期眼科检查,在医院接受规范化治疗,多管齐下才能延缓眼底病变,守住光明。
便民小贴士

吕红彬
眼科主任兼视光科负责人
眼科学教研室主任
医学博士,主任医师
三级教授,博士研究生导师
从事眼科医疗、教学和科研工作34年,擅长各种玻璃体视网膜手术和屈光手术,对眼底病、屈光、视光、白内障、青光眼、眼外伤以及眼眶病等的诊治具有较高的造诣。
(来源:西南医科大学附属医院 文:周琦 吕红彬 图:雷颖庆 陈璐)
编辑:游江
关注川南在线网微信公众号
长按或扫描二维码 ,获取更多最新资讯
其他